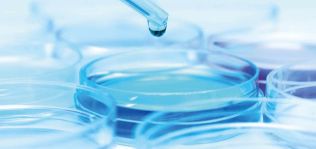
Recordati completa la adquisición de Eusa Pharma por 707 millones

Recordati consolida su estructura con cuatro nuevos directores en su sede de Madrid
La compañía italiana ha remodelado la cúpula de su negocio en España para continuar impulsando su crecimiento. Los nuevos nombramientos liderarán áreas como estrategia, comercial o I+D y el comité tendrá nueve miembros.


David Marín, Cristina Fernández, David Mora, Carmen Leal, Javier Carpintero, Ellina Tsymbal, Julián Saiz, María Vivancos y Robert Edwards.
17 dic 2024 - 13:36
Recordati refuerza su dirección en España. La filial española del grupo italiano ha reordenado su cúpula en el país, concretamente con cuatro nuevos directivos en su sede de Madrid con el objetivo de continuar impulsando su crecimiento.
Ahora, el área de estrategia y commercial excellence estará liderada por Robert Edwards, que cuenta con una década de trayectoria en el sector farmacéutico. También será el responsable de ejecutar la implementación del plan estratégico de la compañía en España.
Por su parte, Ellina Tsymbal se incorpora como nueva directora del departamento médico e I+D de Recordati. Su misión será liderar las áreas terapéuticas prioritarias como urología, gastroenterología, pediatría, psiquiatría o atención primaria, entre otras.
El otro departamento de Recordati que cuenta con una nueva dirección es el de legal y compliance, que estará pilotado por Cristina Fernández. Por último, David Marín se responsabilizará de la dirección de la unidad de negocio de urología, gastroenterología y psiquiatría.
Recordati sumó cuatro nuevos profesionales para liderar áreas como negocios, legales o innovación
Con las nuevas incorporaciones, el comité de dirección de Recordati España queda conformado por nueve integrantes, que reportan directamente al director general, que se sumó al grupo el pasado abril.
“Los nuevos directivos aportan una perspectiva única, valiosa y diversa fortaleciendo aún más nuestras capacidades gracias a sus amplias experiencias y por haber trabajado en compañías de primer nivel”, destacó Javier Carpintero, director general de Recordati España.
Fundada en 1926 en Milán, Recordati cuenta con una filial española en Madrid y un centro de operaciones en Zaragoza. La empresa italiana cuenta allí con su propia planta de fabricación y departamento de investigación y desarrollo de nuevos productos, donde produce más de veinte millones de unidades de venta.
A escala mundial, Recordati lleva a cabo operaciones en todo Europa, así como en Turquía, Estados Unidos, el norte de África y algunos países de Latinoamérica como México. El grupo farmacéutico cotiza en la Bolsa italiana.